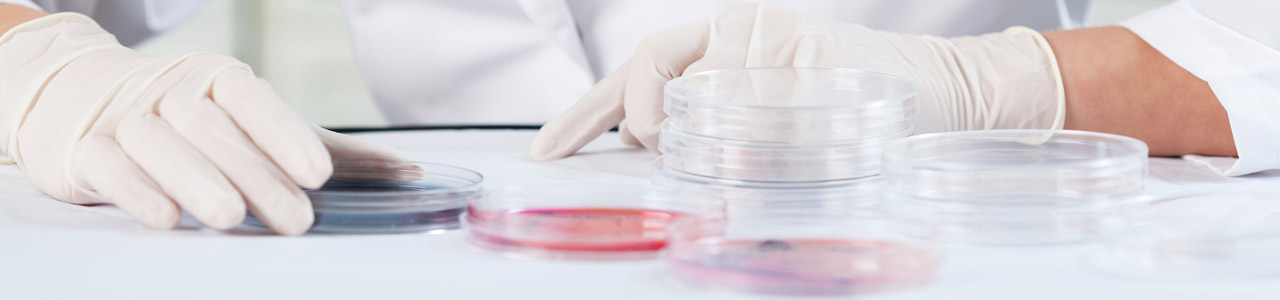

Ready-to-use Agar Media and Broth – Product Range
Custom-made products are also possible for small quantities
The range of ready-to-use M&S nutrient media is geared to the needs of the food and beverage industry.
In case you
- cannot find the nutrient medium you are looking for in the M&S standard range
- need a special composition or a special pH-value for an existing nutrient medium
- would prefer a pack size that is more convenient for your needs
then simply contact us. We will check the feasibility of your wishes and will prepare a non-committal offer.
| Nutrient medium Standard | Item-No. (Size) | Data sheets (DS) to download (pdf) |
|---|---|---|
| Azide Dextrose-Broth, 1 x concentrated, with membrane filters MineralwV, TrinkwV | 5140 (25 Tests) | Technical DS Safety DS |
| Azide Dextrose-Broth, 2 x concentrated TrinkwV | 5010 (4 x 100 ml) | Technical DS Safety DS |
| BAT-Agar with membrane filters | 4012 (24 x 10 ml) 5012 (4 x 125 ml) | Technical DS Safety DS |
| Beer-Agar | 5015 (4 x 250 ml) | Technical DS Safety DS |
| BfB-Broth for Beer spoiling bacteria | 4008 (25 x 20 ml) | Technical DS Safety DS |
| BfW-Broth for Wild yeasts | 4056 (25 x 20 ml) | Technical DS Safety DS |
| Bile Esculin Azide-Agar MineralwV, TrinkwV, EN ISO 7899 | 5250 (25 x 20 ml) 5251 (4 x 250 ml) | Technical DS Safety DS |
| Caso-Agar, TSA EP, USP, DIN EN ISO 9308-1 | 4020 (25 x 20 ml) 5020 (4 x 250 ml) | Technical DS Safety DS |
| Caso-Broth, TSB EP, USP | 4021 (25 x 20 ml) 5023 (4 x 250 ml) | Technical DS Safety DS |
| Cetrimide-Agar DEV, EP, USP | 4025 (25 x 20 ml) 5021 (4 x 250 ml) | Technical DS Safety DS |
| Colichrom-Agar TrinkwV, DIN EN ISO 9308-1 | 4028 (25 x 20 ml) 4028-100 (100 x 20 ml) 5025 (4 x 250 ml) 5025-24 (24 x 250 ml) | Technical DS Safety DS |
| Copper Sulphate-Agar | 5039 (4 x 250 ml) | Technical DS Safety DS |
| Crystal violet-Agar | 4051 (25 x 20 ml) 5038 (4 x 250 ml) | Technical DS Safety DS |
| Diastaticus-Agar | 4027 (25 x 20 ml) 4027-100 (100 x 20 ml) | Technical DS Safety DS |
| Diastaticus-Broth, with Durham tube | 4029 (25 x 20 ml) 4029-100 (100 x 20 ml) | Technical DS Safety DS |
| DRCM-Broth, dehydrated MineralwV, TrinkwV | 4030 (25 Tests, 20 ml samples) 5160 (25 Tests, 50 ml samples) | Technical DS Safety DS |
| Endo-Agar APHA | 4040 (25 x 20 ml) 5030 (4 x 250 ml) | Technical DS Safety DS |
| Enterococcus Selective-Agar Slanetz und Bartley MineralwV, TrinkwV, EN ISO 7899 | 5240 (25 x 20 ml) 5241 (4 x 250 ml) | Technical DS Safety DS |
| Gelatine-Agar MineralwV, TrinkwV | 4045 (25 x 20 ml) 4045-100 (100 x 20 ml) 5035 (4 x 250 ml) 5035-24 (24 x 250 ml) | Technical DS Safety DS |
| King B-Agar MineralwV, TrinkwV | 5270 (25 x 20 ml) 5271 (4 x 250 ml) | Technical DS Safety DS |
| Lactose-Broth, 1 x concentrated, with Durham tube and membrane filters MineralwV, TrinkwV | 5130 (25 Tests) | Technical DS Safety DS |
| Lactose-Broth, 2 x concentrated TrinkwV | 5040 (4 x 100 ml) 5040-24 (24 x 100 ml) | Technical DS Safety DS |
| Lactose-Broth, 6 x concentrated | 5044 (4 x 250 ml) 5044-24 (24 x 250 ml) | Technical DS Safety DS |
| Lysine-Agar | 4055 (25 x 20 ml) 5042 (4 x 250 ml) | Technical DS Safety DS |
| Malachite Green-Broth, 1 x concentrated, with membrane filters MineralwV, TrinkwV | 5150 (25 Tests) | Technical DS Safety DS |
| Malachite Green-Broth, 2 x concentrated MineralwV | 5050 (4 x 100 ml) 5050-24 (24 x 100 ml) | Technical DS Safety DS |
| Malt Extract-Agar | 4060 (25 x 20 ml) 4060-100 (100 x 20 ml) 5060 (4 x 250 ml) 5060-24 (24 x 250 ml) | Technical DS Safety DS |
| Malt-Broth, with Durham tube | 4058 (25 x 20 ml) 5059 (4 x 250 ml) | Technical DS Safety DS |
| MRS-Agar | 4061 (25 x 20 ml) 4061-100 (100 x 20 ml) 5061 (4 x 250 ml) 5061-24 (24 x 250 ml) | Technical DS Safety DS |
| MRS-Broth | 4062 (25 x 20 ml) 5062 (4 x 250 ml) | Technical DS Safety DS |
| MRS-Broth, with indicator | 5063 (4 x 250 ml) | Technical DS Safety DS |
| Nutrient-Agar TrinkwV, DEV, DIN EN ISO 16266 | 4080 (25 x 20 ml) 4080-100 (100 x 20 ml) 5080 (4 x 250 ml) 5080-24 (24 x 250 ml) | Technical DS Safety DS |
| Nutrient-Broth Sterility test, e.g. | 4090 (25 x 20 ml) 5081 (4 x 250 ml) | Technical DS Safety DS |
| Orangeserum-Agar APHA | 4095 (25 x 20 ml) 5085 (4 x 250 ml) 5085-24 (24 x 250 ml) | Technical DS Safety DS |
| Orangeserum-Agar pH 3.4, with tartaric acid | 4097 (21 x 20 ml) | Technical DS Safety DS |
| Plate Count-Agar APHA | 4100 (25 x 20 ml) 5090 (4 x 250 ml) 5090-24 (24 x 250 ml) | Technical DS Safety DS |
| Pseudomonas CN-Agar TrinkwV, DIN EN ISO 16266 | 5280 (25 x 20 ml) 5281 (4 x 250 ml) | Technical DS Safety DS |
| R2A-Agar EP, USP | 4125 (25 x 20 ml) 5095 (4 x 250 ml) | Technical DS Safety DS |
| Rinsing solution | 5129-24 (24 x 250 ml) | Technical DS Safety DS |
| Rinsing solution, with Tween | 5128-24 (24 x 250 ml) | Technical DS Safety DS |
| RV-Broth | 4007 (25 x 10 ml) 5097 (4 x 250 ml) 5097-24 (24 x 250 ml) | Technical DS Safety DS |
| RV-Broth, with Swabs | 4017 (60 Tests) | Technical DS Safety DS |
| Sabouraud-Agar ILV, EP, USP | 4130 (25 x 20 ml) 5100 (4 x 250 ml) | Technical DS Safety DS |
| Standard-Agar | 4135 (25 x 20 ml) 4135-100 (100 x 20 ml) 5101 (4 x 250 ml) 5101-24 (24 x 250 ml) | Technical DS Safety DS |
| Tryptophane Peptone-Water TrinkwV, DIN EN ISO 9308-1 | 5220 (25 x 10 ml) | Technical DS Safety DS |
| Wort-Agar | 4150 (25 x 20 ml) 5110 (4 x 250 ml) 5110-24 (24 x 250 ml) | Technical DS Safety DS |
| Yeast Extract-Agar TrinkwV, DIN EN ISO 6222 | 4047 (25 x 20 ml) 4047-100 (100 x 20 ml) 5036 (4 x 250 ml) 5036-24 (24 x 250 ml) | Technical DS Safety DS |
| YGC-Agar | 4170 (25 x 20 ml) 5120 (4 x 250 ml) | Technical DS Safety DS |